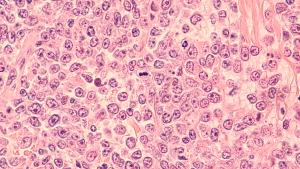

New 48-week results from the Phase IIIb APEX trial show Tremfya delivers sustained radiographic protection and deeper clinical responses in active psoriatic arthritis, reinforcing its potential as an early, structural-sparing therapy.

New 48-week results from the Phase IIIb APEX trial show Tremfya delivers sustained radiographic protection and deeper clinical responses in active psoriatic arthritis, reinforcing its potential as an early, structural-sparing therapy.

Epkinly plus rituximab and lenalidomide is the first bispecific antibody combination FDA-approved for relapsed or refractory follicular lymphoma, backed by Phase III data showing substantially improved disease control over standard therapy.

FDA approves COVID-19 vaccines from Moderna, Pfizer-BioNTech, and Novavax targeting the LP.8.1 sublineage of SARS-CoV-2, with eligibility limited to adults aged 65 years and older and those with underlying medical conditions that place them with a high risk for severe disease.

The Phase II RAINBOWFISH study found that infants treated with Evrysdi (risdiplam) within six weeks of birth reached major motor milestones over two years.

Results from the Phase III KEYNOTE-689 trial show that adding perioperative Keytruda (pembrolizumab) to standard-of-care radiotherapy improves event-free survival in patients with resectable, locally advanced head and neck squamous cell carcinoma, potentially setting a new benchmark for treatment in this setting.

Once-weekly cagrilintide–semaglutide combination therapy produced unprecedented weight reductions in adults with overweight or obesity, with 60% achieving ≥20% loss and strong cardiometabolic benefits, according to Phase IIIa trial results published in The New England Journal of Medicine.

The global Phase III PROMINENT trial has begun dosing patients to evaluate felzartamab in treating primary membranous nephropathy, a serious autoimmune kidney disorder with no FDA-approved therapies.

Updated results from the Phase II RedirecTT-1 trial show that the dual bispecific antibody regimen of Talvey and Tecvayli delivers deep, lasting responses in patients with triple-class exposed relapsed or refractory multiple myeloma and true extramedullary disease.

Although the SYMMETRY Phase IIb trial of the FGF21 analogue efruxifermin did not meet its primary endpoint at 36 weeks, extended 96-week data suggest potential benefits in fibrosis reduction and liver health in patients with compensated cirrhosis due to MASH, supporting continued evaluation in Phase III studies.

Detailed Phase IIIb STEP UP trial results presented at the 2025 ADA Scientific Sessions found that an investigational 7.2 mg dose of Wegovy (semaglutide) led to a mean weight loss of 21% in adults with obesity and no diabetes, showing the potential to expand dosing options in obesity management.

In a Phase II trial, Amgen’s investigational therapy MariTide (maridebart cafraglutide) delivered significant, sustained weight loss of up to 20% in adults with obesity, with or without type 2 diabetes, alongside notable improvements in glycemic control, supporting its advancement to Phase III studies as a potential once-monthly treatment option.

New Phase III data published in The New England Journal of Medicine show elinzanetant, a nonhormonal dual NK-1/NK-3 receptor antagonist, significantly reduced vasomotor symptoms, improved sleep, and enhanced quality of life for women undergoing endocrine therapy for HR-positive breast cancer.

Primary results from the Phase II TRANSCEND FL trial show Breyanzi (lisocabtagene maraleucel) achieved a 95.5% response rate and durable efficacy in relapsed or refractory marginal zone lymphoma, supporting its potential as a transformative CAR T-cell therapy.

New data from the POETYK PsA-Phase III trial, presented at the 2025 EULAR Congress, demonstrate that Bristol Myers Squibb’s Sotyktu (deucravacitinib) significantly improves joint and skin symptoms in adults with active psoriatic arthritis, maintaining efficacy through 52 weeks of treatment.

Data from the Phase IIIb APEX study, presented at EULAR 2025, show that guselkumab (Tremfya) improved joint and skin symptoms and inhibited structural joint damage in patients with active psoriatic arthritis, reinforcing its role as a leading IL-23 inhibitor for long-term disease control.

Phase III DeLLphi-304 results show T-cell engager Imdelltra (tarlatamab) delivers superior overall survival, improved progression-free survival, and better symptom control compared to chemotherapy in patients with small-cell lung cancer following platinum-based treatment.

Phase II CONFIDENCE study data reveal that simultaneous initiation of Kerendia and Jardiance significantly improves UACR and delays chronic kidney disease progression in patients with type 2 diabetes.

New data from the IRAKLIA and IZALCO trials, presented at the 2025 ASCO Annual Meeting, demonstrate that subcutaneous Sarclisa delivered via an on-body delivery system offers non-inferior efficacy to IV infusion in patients with relapsed or refractory multiple myeloma, while significantly reducing infusion-related reactions and improving patient satisfaction.

Interim results from the global MATTERHORN study mark the first time an immunotherapy has demonstrated statistically significant event-free survival in a Phase III trial for resectable gastric and gastroesophageal junction cancers, signaling a potential shift in standard perioperative care.

Phase III data presented at ASCO 2025 and published in The New England Journal of Medicine show that Pfizer’s Braftovi (encorafenib), combined with Erbitux (cetuximab) and mFOLFOX6, significantly improves overall survival and progression-free survival in treatment-naïve patients with BRAF V600E-mutant metastatic colorectal cancer—potentially establishing a new first-line standard-of-care for this high-risk population.

Five- and eight-year trial data to be presented at ASCO demonstrate durable survival outcomes with Xtandi (enzalutamide) plus ADT, reinforcing its role as a frontline standard in metastatic hormone-sensitive prostate cancer.

Data from the FIBRONEER-IPF and FIBRONEER-ILD studies, published in The New England Journal of Medicine, highlight nerandomilast’s potential as a first-in-class PDE4B inhibitor for idiopathic and progressive pulmonary fibrosis, demonstrating efficacy as monotherapy or with existing antifibrotics.

The FDA’s Oncologic Drugs Advisory Committee voted against an application for Columvi (glofitamab) plus GemOx for relapsed/refractory diffuse large B-cell lymphoma due to concerns about the applicability of multiregional trial data to the US patient population.

Results from the pivotal BATURA trial show that Airsupra (albuterol/budesonide) significantly outperformed albuterol monotherapy in reducing severe asthma exacerbations and systemic corticosteroid exposure, reinforcing its role as a next-generation, anti-inflammatory rescue therapy for mild asthma patients.

The global, randomized IDeate-Esophageal01 study will evaluate ifinatamab deruxtecan, a B7-H3–targeted antibody-drug conjugate, versus physician’s choice of chemotherapy in patients with advanced or metastatic esophageal squamous cell carcinoma following progression on platinum-based chemotherapy and immune checkpoint inhibitors.

In the TAK-861-2001 Phase IIb study, oveporexton significantly improved wakefulness, daytime sleepiness, and cataplexy frequency in patients with narcolepsy type 1, outperforming current therapies and avoiding liver toxicity seen with earlier OX2R agonists, according to results published in The New England Journal of Medicine.

Merck’s Phase III KEYNOTE-B96 trial shows significant overall and progression-free survival gains with Keytruda plus chemotherapy in patients with PD-L1–positive, platinum-resistant recurrent ovarian cancer, marking a breakthrough for immune checkpoint inhibitors in this hard-to-treat population.

Decision follows underwhelming Phase II results from GALAXIES Lung-201 and H&N-202 trials, prompting iTeos and GSK to end development of the TIGIT-targeting antibody and halt enrollment in all ongoing belrestotug studies.

Final overall survival results from the Phase III APHINITY trial show a 17% reduction in the risk of death at 10 years for patients with HER2-positive early-stage breast cancer treated with a Perjeta-based adjuvant regimen.

In the first head-to-head comparison of leading incretin-based therapies, Eli Lilly’s dual GIP/GLP-1 receptor agonist tirzepatide (Zepbound) delivered significantly greater and sustained weight loss than semaglutide (Wegovy) over 72 weeks in adults with obesity or overweight and comorbidities.

Published: December 20th 2024 | Updated:

Published: July 22nd 2024 | Updated:

Published: February 1st 2024 | Updated:

Published: March 8th 2024 | Updated:

Published: May 31st 2024 | Updated:
Published: April 15th 2024 | Updated: